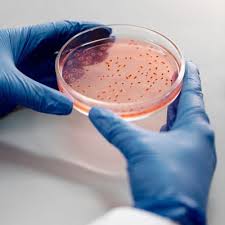
FYUGP B.Sc MICROBIOLOGY (HONOURS)

UG Programmes

Ability Enhancement Courses (AEC - Other Language) offered
Semester 1
|
Offered by |
Offered to |
Title of the Elective |
Course Code |
|
Hindi |
Science Departments |
Environment in Hindi Literature |
MG1AECHIN100 |
|
Humanities Departments |
New Media in Hindi Stories |
MG1AECHIN101 |
|
|
Commerce Department |
Drama And Communicative Hindi |
MG1AECHIN102 |
|
|
Malayalam |
Science Departments |
Sahitheemalika |
MG1AECMAL100 |
|
Humanities Departments |
Sargasaahithi |
MG1AECMAL101 |
|
|
Commerce Department |
Bhashasaahithi |
MG1AECMAL102 |
|
|
Sanskrit |
Science Departments |
Communicative skills and scientific studies in Sanskrit |
MG1AECSAN100 |
|
Humanities Departments |
Introduction of Sanskrit language and literature |
MG1AECSAN101 |
|
|
Commerce Department |
Fundamental Sanskrit |
MG1AECSAN102 |
|
|
German |
Elementary German I |
MG1AECGER100 |
Ability Enhancement Courses (AEC - Other Language) offered
Semester 2
|
Offered by |
Offered to |
Title of the Elective |
Course Code |
|
Hindi |
Science Departments |
New text New Aesthetics | MG2AECHIN100 |
|
Humanities Departments |
Harmony of Festivals | MG2AECHIN101 | |
|
Commerce Department |
Modern Hindi Prose and Translation | MG2AECHIN102 | |
|
Malayalam |
Science Departments |
കലാമഞ്ജരി | MG2AECMAL100 |
|
Humanities Departments |
ദൃശ്യപഥം | MG2AECMAL101 | |
|
Commerce Department |
ഗദ്യരാജി |
MG2AECMAL102 |
|
|
Sanskrit |
Science Departments |
Poetic Appreciation of Sanskrit Literature |
MG2AECSAN100 |
|
Humanities Departments |
Ancient and Modern Literature in Sanskrit |
MG2AECSAN101 |
|
|
Commerce Department |
Discourses and Poetical Functions of Sanskrit |
MG2AECSAN102 |
|
|
German |
Science Departments |
Elementary German 2 |
MG2AECGER100 |
Minor Courses offered
Semester 1
| Offered by | Title of the Course | Code |
| Botany | Fascinating world of Plant Sciences | MG1DSCBOT100 |
| Chemistry | Fundamentals of Chemistry 1 | MG1DSCCHE100 |
| Commerce | Marketing Management | MG1DSCBST100 |
| Commerce | Corporate Regulations and Compliance | MG1DSCBLW100 |
| Commerce | Basic Finance for Daily Life | MG1DSCCOM100 |
| Computer Science | Art of Computing and Problem Solving | MG1DSCCSC100 |
| Computer Application | Introduction to Web Designing | MG1DSCCMA101 |
| English | Anglo-Saxon Aesthetics to Renaissance Rhetoric: Makers of English Literature | MG1DSCLIH100 |
| English | Malayalam Literature in English Translation | MG1DSCTRS100 |
| English | Literary Genres: Poetry, Fiction and Folk Tales | MG1DSCENG100 |
| Hindi | Linguistics – An Introduction | MG1DSCLGS100 |
| Hindi | Graphic Design and Typography in Hindi | MG1DSCFHI100 |
| History | Introducing History | MG1DSCHIS100 |
| Politics | Everyday Politics | MG1DSCPOL100 |
| Mathematics | Ground Roots of Mathematics | MG1DSCMAT100 |
| Physics | Foundations of Physics | MG1DSCPHY100 |
| Sanskrit | An Introduction to Sanskrit Language and Literature | MG1DSCSAN101 |
| Sanskrit | सरलसंस्कृतदिशा वेदान्तपरिचयः | MG1DSCSSD100 |
| Statistics | Fundamentals of Statistics and Data Visualisation | MG1DSCSTA100 |
| Zoology | Introduction to Zoology | MG1DSCZGY100 |
| Microbiology | Unseen World of Microbes | MG1DSCMBG100 |
| Biotechnology | Fundamentals for Biotechnology | MG1DSCBTG100 |
| Biochemistry | The Science of Life | MG1DSCBCH100 |
Minor Courses offered
Semester 2
| Offered by | Title of the Course | Code |
| BOTANY | Plant resources and ventures in botany | MG2DSCBOT100 |
| CHEMISTRY | Fundamentals of Chemistry - 2 | MG2DSCCHE100 |
| COMMERCE | Business Regulatory Framework | MG2DSCBLW100 |
| COMMERCE | Business and Sustainable Development | MG2DSCBST100 |
| COMPUTER SCIENCE | Python Programming | MG2DSCCSC100 |
| COMPUTER APPLICATION | AI-Powered Presentation Tools and Techniques | MG2DSCCMA100 |
| COMMERCE | Indian Securities Market - Structure and Operations | MG2DSCCOM100 |
| ENGLISH(SELF MINOR) | From Restoration Rationalism to Romantic Rhapsodies (Makers of English Literature) | MG2DSCLIH100 |
| ENGLISH(SELF MINOR) | Indian Literatures in English Translation | MG2DSCTRS100 |
| ENGLISH | Literary Genres: Prose, Drama, Film | MG2DSCENG100 |
| ECONOMICS | Essentials Of Economics ll | MG2DSCECO100 |
| HINDI | Introduction to Phonetics | MG2DSCLGS100 |
| HINDI(SELF MINOR) | Functional Hindi | MG2DSCFHI100 |
| HISTORY | Themes in Global History | MG2DSCHIS100 |
| MATHEMATICS | A Gateway to Mathematics | MG2DSCMAT100 |
| PHYSICS | Modern Physics | MG2DSCPHY100 |
| POLITICAL SCIENCE | Introduction to Indian Constitution | MG2DSCPOL100 |
| SANSKRIT(SELF MINOR) | Poetry, Drama and Basics of Grammar | MG2DSCSAN100 |
| SANSKRIT | Applied Vedanta Literature | MG2DSCSSD100 |
| STATISTICS | Introduction to Statistical Modelling | MG2DSCSTA100 |
| ZOOLOGY | Environmental Biology | MG2DSCZGY100 |
Minor Courses offered
Semester 3
|
Offered by |
Title of the Elective |
Course Code |
| Chemistry | Inorganic and Organic Chemistry |
MG3DSCCHE202 |
| Commerce | Entrepreneurship and Startups | MG3DSCBST200 |
| Computer Application | AI Techniques for Data Analysis | MG3DSCCMA200 |
| English | Detective Fiction | MG3DSCENG202 |
| Hindi | Art of Letter Writing | MG3DSCFHI200 |
| History | Origins of the Modern World | MG3DSCHIS202 |
| Politics | Human Rights in India | MG3DSCPOL203 |
| Mathematics | Essentials of Applied Mathematics | MG3DSCMAT202 |
| Physics | Atomic and Molecuar Spectroscopy | MG3DSCPHY202 |
| Sanskrit | Vedantasastraparichaya | MG3DSCSSD202 |
| Statistics | Data Analysis in Inferential Statistics Using R/Python | MG3DSCSTA202 |
| Microbiology(SF) | Techniques in Microbiology | MG3DSCMBG202 |
| Biotechnology(SF) | Fundamentals of Molecular Biology | MG3DSCBTG202 |
| Biochemistry(SF) | Techniques in Biochemistry and Forensic Science | MG3DSCBCH202 |
Minor Courses offered
Semester 4
|
Offered by |
Title of the Elective |
Course Code |
| Chemistry | Fundamentals of Physical Chemistry | MG4DSCCHE202 |
| Commerce (self minor) | Business and Taxation Laws | MG4DSCBLW200 |
| Computer Science | Introduction to Database Management Systems | MG4DSCCSC202 |
| English (self Minor) | Modes of Modernism and Poetics of the Postmodern: Makers of English Literature | MG4DSCLIH200 |
| Hindi (self Minor) | Introduction to Syntax | MG4DSCLGS200 |
| Economics | Economics of Marketing | MG4DSCECO202 |
| Political Science | Constitutional and Statutory Bodies in India | MG4DSCPOL202 |
| Botany | Introduction to flowering plants and their economic importance | MG4DSCBOT202 |
| Mathematics | Applied Mathematical Methods | MG4DSCMAT202 |
| Physics | Basic Electronics and Electricity | MG4DSCPHY202 |
| Sanskrit (self minor) | Sanskrit Literature , Logic and Philosophy | MG4DSCSAN200 |
| Zoology | Functional Zoology | MG4DSCZGY202 |
| Biochemistry(SF) | Metabolism of carbohydrates,proteins and lipids | MG4DSCBCH202 |
| Biochemistry(SF) | Techniques in Biochemistry and Forensic Science | MG3DSCBCH202 |
Multi Disciplinary Courses (MDC) offered
Semester 1
|
Offered by |
Title of the Course |
Course Code |
| Botany | Ecotourism | MG1MDCBOT100 |
| Chemistry | Food Chemistry and Nutrition | MG1MDCCHE100 |
| Commerce | Personal Finance and Planning | MG1MDCCOM101 |
| Commerce | Business Organisation and Entrepreneurship | MG1MDCCOM100 |
| English | Narratives of Humour | MG1MDCENG101 |
| English | Content Writing | MG1MDCENG102 |
| English | Folk Tales and Songs from India | MG1MDCENG100 |
| Hindi | Green Journey | MG1MDCHIN101 |
| Malayalam | Madhyamapadanam | MG1MDCMAL100 |
| Mathematics | Mathematics for Competitive Examinations | MG1MDCMAT100 |
| Physics | Physics around you | MG1MDCPHY100 |
| Sanskrit | Vrikshayurveda | MG1MDCSSD100 |
| Statistics | Data Analysis using Libre Calc | MG1MDCSTA101 |
| Zoology | Ornamental Fish Farming and Aquarium Keeping | MG1MDCZGY100 |
| Microbiology | Fascinating World of Microbes | MG1MDCMBG100 |
| Biotechnology | Ecology and Environmental Science | MG1MDCBTG100 |
| Biochemistry | Sports Biochemistry- The Science of Exercise and Human Performance | MG1MDCBCH100 |
Multi Disciplinary Courses (MDC) offered
Semester 2
|
Offered by |
Title of the Course |
Course Code |
| CHEMISTRY | Dairy Chemistry | MG2MDCCHE100 |
| COMMERCE | Event Management | MG2MDCCOM101 |
| COMMERCE | Fundamentals of Accounting | MG2MDCCOM100 |
| ENGLISH | Fundamentals of Advertising and Public Relations | MG2MDCENG102 |
| ENGLISH | Narratives of Love and Friendship | MG2MDCENG100 |
| ENGLISH | Sports Literature and Cinema | MG2NDCENG101 |
| HINDI | Women in Contemporary Hindi Cinema | MG2MDCHIN102 |
| MATHEMATICS | Applicable Mathematics | MG2MDCMAT100 |
| MALAYALAM | ജനപ്രിയസംസ്കാരം | MG2MDCMAL101 |
| PHYSICS | Observational Astronomy | MG2MDCPHY100 |
| SANSKRIT | अनुप्रयुक्तयोगः (Practical Yoga) | MG2MDCSSD100 |
Multi Disciplinary Courses (MDC) offered
Semester 3
|
Offered by |
Title of the Course |
Course Code |
| Hindi | Equality, Freedom and Brotherhood | MG3MDCHIN200 |
| Malayalam | കേരളപഠനം | MG3MDCMAL200 |
| English | Literature and Kerala Renaissance | MG3MDCENG200 |
Value Added Courses (VAC) offered
Semester 3
|
Offered by |
Title of the Course |
Course Code |
| Chemistry | Forensic Chemistry | MG3VACCHE200 |
| Hindi | We Are One | MG3VACHIN200 |
| Malayalam | അതിജീവനപാഠങ്ങൾ | MG3VACMAL200 |
| Political Science | Secularism and Cultural Diversity | MG3VACPOL200 |
| Biochemistry(SF) | Microplastics and environment | MG3VACBCH200 |
|
English
|
Litearture and Gender | MG3VACENG200 |
| Literature, Technology and AI | MG3VACENG201 | |
| Kalpavriksha: Exploring India through Stories, Songs, Science and Soul (Signature course) | MG3VACENGA00 |
Value Added Courses (VAC) offered
Semester 4
|
Offered by |
Title of the Course |
Course Code |
| Chemistry | Basic Environmental Chemistry | MG4VACCHE200 |
| Hindi | Let Gandhi live, Let Peace Prevail | MG4VACHIN200 |
| Malayalam | Samoohyaneethipatanam | MG4VACMAL201 |
| Political Science | Legal Literacy and Legal Awareness | MG4VACPOL200 |
| Biochemistry(SF) | Narcotics and Psychotropic Substances (NDPS) | MG4VACBCH200 |
|
English
|
Literature and Environment | MG4VACENG200 |
| Literature and Law | MG4VACENG201 |
Skill Enhancement Courses (SEC) offered
Semester 4
|
Offered by |
Title of the Course |
Course Code |
| Hindi | Let's Speak Hindi | MG4SECHIN200 |
| Malayalam | Mathsarappareekshakalile Malayalam | MG4SECMAL201 |
|
English
|
English for International Careers | MG4SECENG200 |
| English for Professional Purposes | MG4SECENG201 | |
| Biochemistry(SF) | Biochemical Tests in Disease Diagnosis | MG4SECBCH200 |